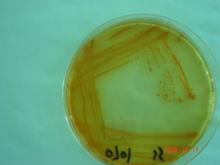
沙門氏菌屬

介紹
中文學名: 沙門氏菌屬
拉丁學名:(Salmonella,1900)
 沙門氏菌屬的生化特徵
沙門氏菌屬的生化特徵形態描述:直桿菌,0.7~1.5μm×2.0~5.0μm,符合腸桿菌科的一般定義。革蘭氏陰性。通常運動(周生鞭毛)。兼性厭氧。菌落直徑一般2~4mm。硝酸鹽還原到亞硝酸鹽。通常從葡萄糖產氣,常在三糖鐵瓊脂上產生硫化氫,吲哚陰性,常利用檸檬酸鹽作為惟一碳源。通常賴氨酸和鳥氨酸脫羧酶反應陽性。脲酶陰性。苯丙氨酸和色氨酸不氧化脫氨。通常不發酵蔗糖、水楊苷、肌醇和扁桃苷。不產生脂酶和脫氧核糖核酸酶。對人致病,引起腸傷寒,腸胃炎和敗血症,也可能傳染人類以外的其他多種動物。某些血清變型是嚴格的寄主適應型。
DNA的G+G mol%是50~53(HPLC,Tm,Bd)(Hill,1966)。亞屬間的區分見表3-7。
沙門氏菌屬
沙門氏菌屬模式種:豬霍亂沙門氏菌(Salmonella choleraesuis)。
Salmonella
腸桿菌科的 1屬。因美國病理學家D.E.沙門於1884年發現本屬菌中的豬霍亂桿菌而得名。本屬菌是一群抗原構造和生物學性狀相似的革蘭氏陰性桿菌。菌型繁多,已發現有2000種以上的血清型。能對人和少數溫血動物致病。
菌體大小(0.6~0.9)×(1~3)微米無芽胞,一般無莢膜,除雞白痢沙門氏菌和雞傷寒沙門氏菌外,大多有周身鞭毛。營養要求不高,分離培養常採用腸道選擇鑑別培養基。生化反應對本屬菌的鑑別具有重要參考意義(見表)。不液化明膠,不分解尿素,不產生吲哚,不發酵乳糖和蔗糖,能發酵葡萄糖、甘露醇、麥芽糖和衛芽糖,大多產酸產氣,少數隻產酸不產氣。VP試驗陰性,有賴氨酸脫羧酶。DNA的G+C含量為50~53%。對熱抵抗力不強,在60℃15分鐘可被殺死。在水中存活2~3周。在5%的石炭酸中,5分鐘死亡。
本屬菌按生化反應分為 4個亞屬。亞屬Ⅰ是生化反應典型的和最常見的沙門氏菌;亞屬Ⅱ和Ⅳ是生化反應不典型的沙門氏菌;亞屬Ⅲ是亞利桑那沙門氏菌。
沙門氏菌具有複雜的抗原結構,一般可分為菌體(O)抗原、鞭毛(H)抗原和表面(Vi)抗原3種。
傳染通道
沙門氏菌通過消化道傳染致病,統稱為沙門氏菌病。引起人類疾病的沙門氏菌大多屬於A、B、C、D、E5個血清群,病型有①傷寒與副傷寒(統稱腸熱症):由傷寒沙門氏菌、甲型和乙型副傷寒沙門氏菌等引起;②食物中毒:可由不同菌型引起,以鼠傷寒沙門氏菌、腸炎沙門氏菌、湯卜遜沙門氏菌等最為常見;③敗血症:由豬霍亂沙門氏菌等引起,此外,還可引起慢性腸炎。
對禽獸致病的沙門氏菌大多屬於B~E血清群。以侵害幼年動物為主,發生急性敗血症、胃腸炎以及其他局部炎症。對成年動物常引起局部慢性或隱性疾病。患沙門氏菌病痊癒的動物具有一定的免疫力。能抗再感染。但局部慢性患病的動物免疫力不強,在疾病恢復期間常成為帶菌者。目前,對豬傷寒、馬流產等11種傳染病已使用菌苗。
血清型
性質
沙門氏菌的抗原分為菌體抗原(O)、鞭毛抗原(H)、莢膜抗原(K、Vi)、纖毛抗原。
O抗原
O抗原存在於菌體細胞壁最外層,化學成分為類脂-多糖-多肽複合物,由多糖決定其特異性。
O抗原耐熱、醇和酸,100~121℃加熱2.5h、用乙醇或鹽酸處理而不失去抗原性,因此菌體抗原已經被公認為沙門氏菌血清型分型的基礎。
一種菌體有一種或多種不同的O抗原。
沙門氏菌的O抗原共有65種,以阿拉伯數字1、2、3……表示。
主要抗原:O 抗原為某一菌群特有而其他菌群不具有。如:2 、3 、4 、7 、8 、9 、10 等。
次要抗原:O 抗原為幾個菌群共有。如:1 、5 、6 、12 等。
H抗原
H抗原存在於鞭毛之中,為蛋白質,由肽鏈中胺基酸的排列順序及空間構型決定其特異性。
 沙門氏菌屬螢光定量PCR檢測試劑盒
沙門氏菌屬螢光定量PCR檢測試劑盒不耐熱,經加熱和用乙醇及鹼處理易變性。H抗原常有兩相的變異。第一相為特異相,用小寫英文字母表示,如:a、b、I、e、h等;第二相為非特異相,用阿拉伯數字表示,如:1、2、5等,但也有少數菌含有第一相中的抗原e、n、x等成分。
Vi抗原
為O抗原表面的莢膜抗原。具有該抗原的細菌,由於可阻止O抗原與抗體結合,因此不被相應的O血清凝集。
60℃加熱處理或石炭酸處理,雖然該抗原不被滅活,而已從菌體表面脫落,游離於液體中,從而暴露出O抗原,可被O血清凝集。
要進行O凝集反應,必須先洗掉Vi抗原。
纖毛抗原
纖毛抗原是一種比鞭毛更細小的纖維樣結構物,含有蛋白性的抗原物質。纖毛能凝集豚鼠的紅細胞。所有沙門氏菌的纖毛抗原性一樣。
纖毛的存在不影響活菌的凝集性,但含有極豐富的纖毛抗原的菌株,有時也組織O的凝集性。
——血清型資料來源於西北農林科技大學楊保偉老師

